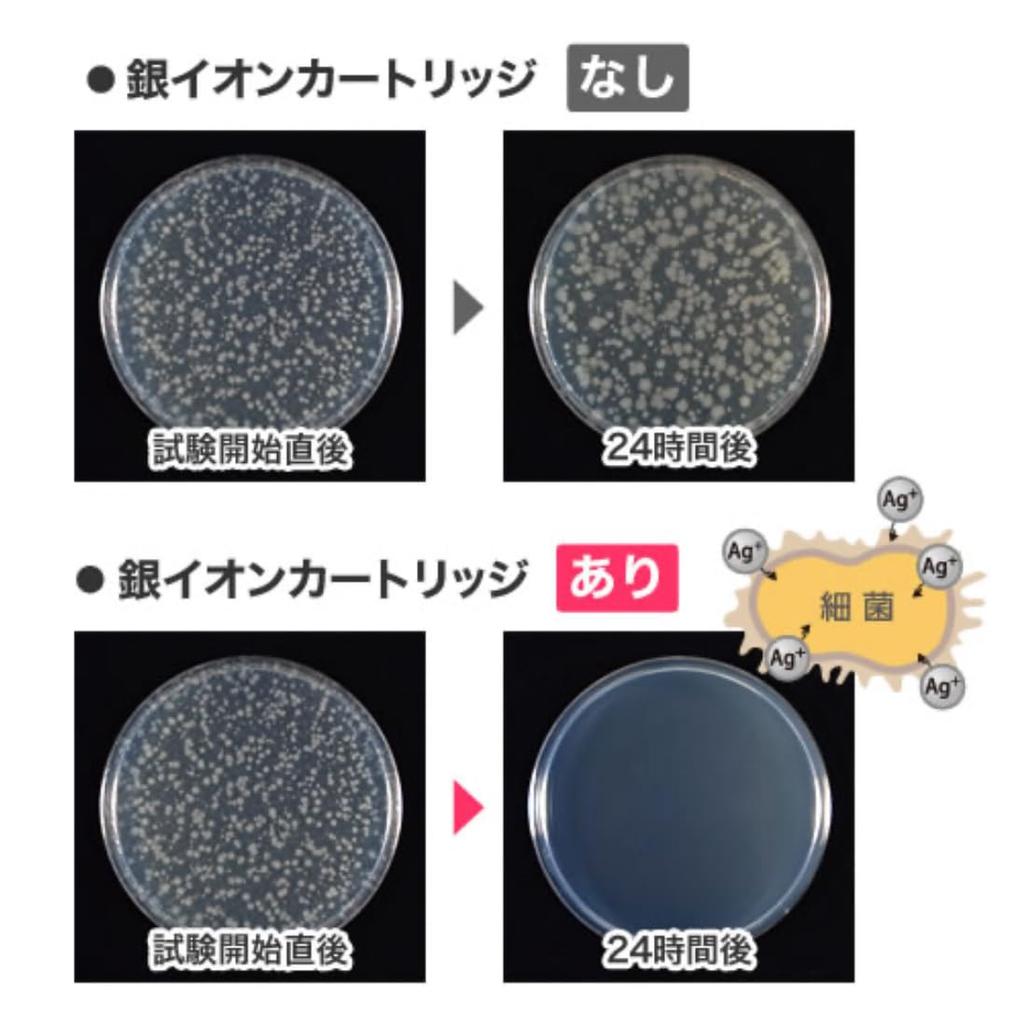
Картридж с ионами серебра Rinnai 820-053-000

Сайт не поддерживает ваш браузер. Пожалуйста, обновите браузер, или скачайте другой
Картридж с ионами серебра Rinnai 820-053-000
Текущая цена
Цена 6 290 ₽ руб.
Бесплатная доставка 26 февраля - 28 марта
Условия возврата
Надежные платежи




Поддержка говорит по-русски
Описание
Похожие товары
Картридж с ионами серебра Rinnai 820-053-000 — купить товар онлайн с бесплатной доставкой до всему миру!
Доступные цвета
Качественные материалы
Качественные фото и реальные отзывы покупателей.
Большой размерный ряд
Интернет-магазин Joom предлагает вам недорогие и качественные товары. Картридж с ионами серебра Rinnai 820-053-000: цены в Joom самые низкие! Много реальных отзывов с фото! Хотите купить товар еще дешевле? Следите за нашими скидками и акциями!